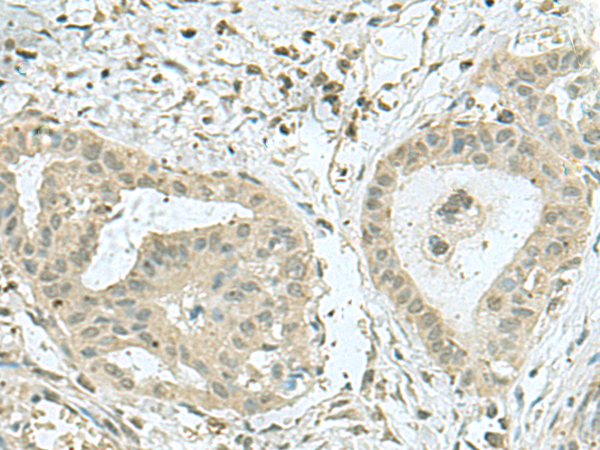

-
分类: 科研抗体货号: P10049别名: C1orf83应用: IHC反应种属: Human, Mouse, Rat
-
分类: 科研抗体货号: P10048别名: PP23; SOUL; C6orf34; C6ORF34B应用: IHC反应种属: Human, Mouse
-
分类: 科研抗体货号: P10064别名:应用: IHC反应种属: Human, Mouse
-
分类: 科研抗体货号: P10047别名: RAB1; YPT1应用: IHC反应种属: Human, Mouse, Rat
-
分类: 科研抗体货号: P10078别名:应用: WB,IHC反应种属: Human
-
分类: 科研抗体货号: P10063别名: THTP; THTPASE应用: IHC反应种属: Human
-
分类: 科研抗体货号: P10046别名: L13A; TSTA1应用: WB,IHC反应种属: Human, Mouse, Rat
-
分类: 科研抗体货号: P10077别名: TRM8; TRMT8; C12orf1; YDL201w应用: IHC反应种属: Human, Mouse
-
分类: 科研抗体货号: P10062别名: HEL-S-303应用: IHC反应种属: Human, Mouse, Rat
-
分类: 科研抗体货号: P10045别名: HsT19268应用: IHC反应种属: Human, Mouse

鄂公网安备42018502007531号
鄂公网安备42018502007531号

